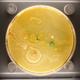
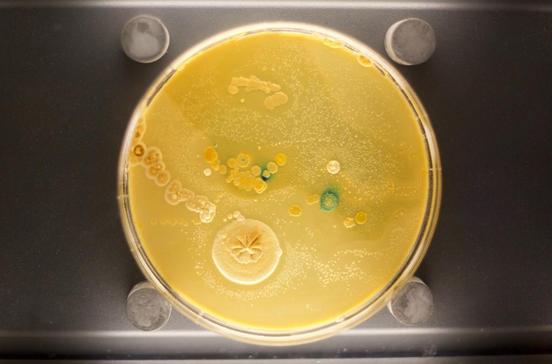

Reiseführer Amsterdam - Waterlooplein & Plantage

Ist erwähnt in Reiseführer:
- Reiseführer
- Europa
- Niederlande
- Nordholland
- Amsterdam
- Amsterdam - Waterlooplein & PlantageSehenswertes & Restaurants
Um den Waterlooplein erstreckt sich das ehemalige Judenviertel, dessen Bewohner im Zweiten Weltkrieg größtenteils deportiert und umgebracht wurden. Geblieben ist nur das Wort Mokum – jiddisch für Heimat und noch heute Spitzname von Amsterdam.
Ab dem 17.Jh. zog es viele Juden in die toleranten Niederlande. Neben den aschkenasischen (deutschstämmigen) Juden lebten im Amsterdamer Judenviertel auch viele sephardische (portugiesischstämmige) Juden. Im Zweiten Weltkrieg bereiteten die Nazis dem florierenden jüdischen Leben ein jähes Ende. Nur 6000 Amsterdamer Juden überlebten das NS-Regime. Übrig geblieben sind mehrere Synagogen und einige Diamantschleifereien.
An das ehemalige jüdische Viertel schließt sich im Osten das noblere, grüne Wohnviertel De Plantage an. Als der Grachtengürtel im 17.Jh. von West nach Ost angelegt wurde, gelangte man nicht über die Amstel hinaus. Östlich vom Fluss lagen stattdessen Gärten und Schiffswerkstätten, die erst im 19.Jh. durch ein großbürgerliches Wohnviertel und das Zollzwischenlager Entrepotdok ersetzt wurden. Heute zieht es Besucher vor allem wegen des Botanischen Gartens oder des Zoos ins grüne Wohnviertel.
Amsterdam - Waterlooplein & Plantage Sehenswertes & Restaurants

Opern
Restaurants
Opern
Restaurants
Zoologische Gärten
Museen
Sonstige Läden
Touristenattraktionen
Botanische Gärten & Parks
Geographical
Märkte und Flohmärkte
Cafés
Het Muziektheater
Opern © MAIRDUMONT
© MAIRDUMONT
Insider-Tipp Konzert zum Nulltarif
Beim Bau 1986 war die moderne Trutzburg am Waterlooplein umstritten. Inzwischen haben sich die Amsterdamer mit ihr abgefunden – bekamen sie zum neuen Rathaus doch auch die einzige Opernbühne der Niederlande. Sie nennen den Monumentalbau Stopera, eine Zusammensetzung aus Stadhuis (Rathaus) und Opera.Im Foyer gibt es von September bis Mai dienstags um 12.30 Uhr kostenlose Lunchkonzerte.
- Waterlooplein 22, 1018 Amsterdam
- http://operaballet.nl/
- +31 20 625 5455
© MAIRDUMONT
© MAIRDUMONT
Insider-Tipp Konzert zum Nulltarif
Beim Bau 1986 war die moderne Trutzburg am Waterlooplein umstritten. Inzwischen haben sich die Amsterdamer mit ihr abgefunden – bekamen sie zum neuen Rathaus doch auch die einzige Opernbühne der Niederlande. Sie nennen den Monumentalbau Stopera, eine Zusammensetzung aus Stadhuis (Rathaus) und Opera.Im Foyer gibt es von September bis Mai dienstags um 12.30 Uhr kostenlose Lunchkonzerte.
- Waterlooplein 22, 1018 Amsterdam
- http://operaballet.nl/
- +31 20 625 5455
De Plantage
Restaurants- international
Flamingos zum Essen! Keine Angst, nicht auf dem Teller, sondern nur in Sichtweite. Im schönsten Wintergarten von Amsterdam wird moderne Bistroküche serviert. Im Sommer sitzt man herrlich auf der großen Terrasse – mit Aussicht auf ein Gehege voller Flamingos und Löffler.
- Plantage Kerklaan 36, 1018 Amsterdam
- http://www.caferestaurantdeplantage.nl/
- +31 20 760 6800
Flamingos zum Essen! Keine Angst, nicht auf dem Teller, sondern nur in Sichtweite. Im schönsten Wintergarten von Amsterdam wird moderne Bistroküche serviert. Im Sommer sitzt man herrlich auf der großen Terrasse – mit Aussicht auf ein Gehege voller Flamingos und Löffler.
- Plantage Kerklaan 36, 1018 Amsterdam
- http://www.caferestaurantdeplantage.nl/
- +31 20 760 6800
Artis
Zoologische Gärten © MAIRDUMONT
Insider-Tipp Amsterdamer Unterwasserwelt
Der Amsterdamer Zoo ist zwar nicht groß, aber dafür alt und sehr schön angelegt. Höhepunkte sind das Schmetterlingshaus, die Seehundfütterung und das alte Aquarium. Eins der Becken bietet einen unerwarteten Einblick: Es bildet den Mikrokosmos einer Amsterdamer Gracht nach, inklusive Fahrrad- und Autowrack, aber auch Plastikmüll. Bis Ende 2025 wird das becken neu aufgestellt. Es soll hohen Ansprüchen an die Nachhaltigkeit gerecht werden und die Bedeutung der Biodiversität in den Vordergrund rücken.
- Plantage Kerklaan 38-40, 1018 Amsterdam
- http://www.artis.nl/
- +31 20 523 3670
- info@artis.nl
© MAIRDUMONT
Insider-Tipp Amsterdamer Unterwasserwelt
Der Amsterdamer Zoo ist zwar nicht groß, aber dafür alt und sehr schön angelegt. Höhepunkte sind das Schmetterlingshaus, die Seehundfütterung und das alte Aquarium. Eins der Becken bietet einen unerwarteten Einblick: Es bildet den Mikrokosmos einer Amsterdamer Gracht nach, inklusive Fahrrad- und Autowrack, aber auch Plastikmüll. Bis Ende 2025 wird das becken neu aufgestellt. Es soll hohen Ansprüchen an die Nachhaltigkeit gerecht werden und die Bedeutung der Biodiversität in den Vordergrund rücken.
- Plantage Kerklaan 38-40, 1018 Amsterdam
- http://www.artis.nl/
- +31 20 523 3670
- info@artis.nl
Joods Historisch Museum
MuseenInsider-Tipp Klassik im Kerzenschein
Wie Holocaustmuseum und Hollandsche Schouwburg ist auch das Joods Museum Teil des Joods Cultureel Kwartier (JCK). Es beschäftigt sich von Spinoza bis Sjabbat mit vielen Facetten der jüdischen Kultur. Zum JM gehört auch das Joods Museum junior mit vielen Programmen speziell für Kinder. Mit demselben Ticket hat man auch Zugang zur Portugiesischen Synagoge. Sie war bei ihrer Eröffnung um 17.Jh. die weltweit größte ihrer Art, bis heute kommen Juden aus aller Welt hier zusammen. Ein stimmungsvolles Erlebnis sind die monatlich hier stattfindenden Kerzenlichtkonzerte.
- Jonas Daniël Meijerplein 2-4, 1001 RE Amsterdam
- http://jck.nl/
- +31 20 531 0310
Insider-Tipp Klassik im Kerzenschein
Wie Holocaustmuseum und Hollandsche Schouwburg ist auch das Joods Museum Teil des Joods Cultureel Kwartier (JCK). Es beschäftigt sich von Spinoza bis Sjabbat mit vielen Facetten der jüdischen Kultur. Zum JM gehört auch das Joods Museum junior mit vielen Programmen speziell für Kinder. Mit demselben Ticket hat man auch Zugang zur Portugiesischen Synagoge. Sie war bei ihrer Eröffnung um 17.Jh. die weltweit größte ihrer Art, bis heute kommen Juden aus aller Welt hier zusammen. Ein stimmungsvolles Erlebnis sind die monatlich hier stattfindenden Kerzenlichtkonzerte.
- Jonas Daniël Meijerplein 2-4, 1001 RE Amsterdam
- http://jck.nl/
- +31 20 531 0310
Hortuswinkel
Sonstige LädenIm Hortuswinkel kann man Blumenzwiebeln und Setzlinge seltener Pflanzen kaufen.
- Plantage Middenlaan 2, 1018 DD Amsterdam
- http://www.dehortus.nl/
- +31 20 625 9021
- info@dehortus.nl
Im Hortuswinkel kann man Blumenzwiebeln und Setzlinge seltener Pflanzen kaufen.
- Plantage Middenlaan 2, 1018 DD Amsterdam
- http://www.dehortus.nl/
- +31 20 625 9021
- info@dehortus.nl
Micropia
Museen © Francesco Proietti, Shutterstock
Insider-Tipp Mehr erfahren zum Thema Zungenkuss
Lebewesen, für die man eigentlich nicht in den Zoo geht: Mikroben, Bakterien und andere Mikroorganismen macht das Museum auf spielerische Weise mit viel Computertechnik und interaktiven Features sichtbar und klärt dabei auch letzte Fragen wie z. B. die, wie Mikroben eigentlich Sex haben. Star der Ausstellung ist der „Kiss-O-Meter“, der misst, wie viele Mikroben bei einem Zungenkuss ausgetauscht werden.
- Plantage Kerklaan 38-40, 1018 CZ Amsterdam
- http://www.micropia.nl/
- +31 20 523 3670
© Francesco Proietti, Shutterstock
Insider-Tipp Mehr erfahren zum Thema Zungenkuss
Lebewesen, für die man eigentlich nicht in den Zoo geht: Mikroben, Bakterien und andere Mikroorganismen macht das Museum auf spielerische Weise mit viel Computertechnik und interaktiven Features sichtbar und klärt dabei auch letzte Fragen wie z. B. die, wie Mikroben eigentlich Sex haben. Star der Ausstellung ist der „Kiss-O-Meter“, der misst, wie viele Mikroben bei einem Zungenkuss ausgetauscht werden.
- Plantage Kerklaan 38-40, 1018 CZ Amsterdam
- http://www.micropia.nl/
- +31 20 523 3670
Blauwbrug
Touristenattraktionen © MarinaD_37, Shutterstock
Ein wenig fühlt man sich bei ihrem Anblick an den Pont Neuf in Paris erinnert. Die Brücke über die Amstel wurde 1884 erbaut. Blau ist die Brücke allerdings nicht: Der Name stammt noch von der blau gestrichenen Holzbrücke, die hier vorher stand.
- Blauwbrug, 1011 Amsterdam
- http://nl.wikipedia.org/
© MarinaD_37, Shutterstock
Ein wenig fühlt man sich bei ihrem Anblick an den Pont Neuf in Paris erinnert. Die Brücke über die Amstel wurde 1884 erbaut. Blau ist die Brücke allerdings nicht: Der Name stammt noch von der blau gestrichenen Holzbrücke, die hier vorher stand.
- Blauwbrug, 1011 Amsterdam
- http://nl.wikipedia.org/
Amsterdams Museum
MuseenDa sein Stammsitz in der Innenstadt bis 2025 renoviert wird, ist das Amsterdam Museum vorerst in einem Flügel der früheren Hermitage zu finden. Zu sehen gibt es eine chronologische Geschichte der Stadt, aber auch Beiträge von zeitgenössischen Künstlern – vom ältesten Stadtplan bis hin zu neuer Street Art.
- Amstel 51, 1018 Amsterdam
- http://www.amsterdammuseum.nl/
- +31 20 523 1822
- info@ahm.amsterdam.nl
Da sein Stammsitz in der Innenstadt bis 2025 renoviert wird, ist das Amsterdam Museum vorerst in einem Flügel der früheren Hermitage zu finden. Zu sehen gibt es eine chronologische Geschichte der Stadt, aber auch Beiträge von zeitgenössischen Künstlern – vom ältesten Stadtplan bis hin zu neuer Street Art.
- Amstel 51, 1018 Amsterdam
- http://www.amsterdammuseum.nl/
- +31 20 523 1822
- info@ahm.amsterdam.nl
Hermitage Amsterdam
Museen © Alexander Zhivitsky, Shutterstock
Dies ist die dritte Auslandsfiliale des berühmten russischen Kunstmuseums nach London und Las Vegas. Sie befindet sich in einem ehemaligen Altenwohnheim aus dem 17.Jh. an der Amstel. Gezeigt werden Stücke aus der umfangreichen Sammlung des Muttermuseums, von altgriechischem Schmuck bis zu Rokokomalerei. Sehenswert sind aber auch der alte Kirchensaal, das Regentenzimmer und vor allem die voll ausgestattete historische Küche des Altenwohnheims.
- Amstel 51, 1018 EJ Amsterdam
- http://www.hartmuseum.nl/
- +31 20 530 8755
© Alexander Zhivitsky, Shutterstock
Dies ist die dritte Auslandsfiliale des berühmten russischen Kunstmuseums nach London und Las Vegas. Sie befindet sich in einem ehemaligen Altenwohnheim aus dem 17.Jh. an der Amstel. Gezeigt werden Stücke aus der umfangreichen Sammlung des Muttermuseums, von altgriechischem Schmuck bis zu Rokokomalerei. Sehenswert sind aber auch der alte Kirchensaal, das Regentenzimmer und vor allem die voll ausgestattete historische Küche des Altenwohnheims.
- Amstel 51, 1018 EJ Amsterdam
- http://www.hartmuseum.nl/
- +31 20 530 8755
Tropenmuseum
Museen © Christophe Cappelli, Shutterstock
Leben und Kultur in tropischen und subtropischen Gebieten sind Thema dieses Museums. Es wurde 1910 als Kolonialmuseum gegründet. Gezeigt wurden lauter Gegenstände, die Niederländer aus den Kolonien in Südostasien und Südamerika mitgebracht hatten. Inzwischen sind im Tropenmuseum die unterschiedlichsten Objekte aus aller Herren Länder versammelt und werden mit Hilfe modernster Multimediatechnik nach Regionen geordnet präsentiert. Zu den Höhepunkten des Hauses gehören die nachgebauten Straßenzüge aus fernen Ländern, etwa ein Slum in Manila.
- Linnaeusstraat 2, 1092 CK Amsterdam
- http://amsterdam.wereldmuseum.nl/
- +31 88 004 2800
- info@tropenmuseum.nl
© Christophe Cappelli, Shutterstock
Leben und Kultur in tropischen und subtropischen Gebieten sind Thema dieses Museums. Es wurde 1910 als Kolonialmuseum gegründet. Gezeigt wurden lauter Gegenstände, die Niederländer aus den Kolonien in Südostasien und Südamerika mitgebracht hatten. Inzwischen sind im Tropenmuseum die unterschiedlichsten Objekte aus aller Herren Länder versammelt und werden mit Hilfe modernster Multimediatechnik nach Regionen geordnet präsentiert. Zu den Höhepunkten des Hauses gehören die nachgebauten Straßenzüge aus fernen Ländern, etwa ein Slum in Manila.
- Linnaeusstraat 2, 1092 CK Amsterdam
- http://amsterdam.wereldmuseum.nl/
- +31 88 004 2800
- info@tropenmuseum.nl
Hortus Botanicus
Botanische Gärten & Parks © MAIRDUMONT
Dies ist beileibe kein gewöhnlicher botanischer Garten. Schon vor mehr als 300 Jahren pflanzten holländische Ärzte an diesem Ort die ersten exotischen Kräuter an, die die einheimischen Kaufleute und Seefahrer von ihren Reisen in die Ferne mitgebracht hatten. Auf dem Gebiet der Tropenmedizin waren sie ihren europäischen Kollegen deshalb bald um eine Nasenlänge voraus. Besonders schön ist das alte Palmenhaus, aber auch das futuristische Gewächshaus ist einen Besuch wert. Im Hortuswinkel kann man Blumenzwiebeln und Setzlinge seltener Pflanzen kaufen.
- Plantage Middenlaan 2, 1018 DD Amsterdam
- http://www.dehortus.nl/
- +31 20 625 9021
- info@dehortus.nl
© MAIRDUMONT
Dies ist beileibe kein gewöhnlicher botanischer Garten. Schon vor mehr als 300 Jahren pflanzten holländische Ärzte an diesem Ort die ersten exotischen Kräuter an, die die einheimischen Kaufleute und Seefahrer von ihren Reisen in die Ferne mitgebracht hatten. Auf dem Gebiet der Tropenmedizin waren sie ihren europäischen Kollegen deshalb bald um eine Nasenlänge voraus. Besonders schön ist das alte Palmenhaus, aber auch das futuristische Gewächshaus ist einen Besuch wert. Im Hortuswinkel kann man Blumenzwiebeln und Setzlinge seltener Pflanzen kaufen.
- Plantage Middenlaan 2, 1018 DD Amsterdam
- http://www.dehortus.nl/
- +31 20 625 9021
- info@dehortus.nl
Plantage
Geographical © Mario Savoia, Shutterstock
Im Osten Amsterdams schließt sich das noble, grüne Wohnviertel De Plantage an. Als der Grachtenring im 17.Jh. von West nach Ost angelegt wurde, gelangte man nicht über die Amstel hinaus. Östlich vom Fluss lagen stattdessen Gärten und Schiffswerkstätten, die erst im 19.Jh. durch ein großbürgerliches Wohnviertel und das Zollzwischenlager Entrepotdok ersetzt wurden. Heute zieht es Besucher v.a. wegen des Tropenmuseums, des Zoos oder des Botanischen Gartens ins grüne Wohnviertel. Aber auch das Entrepotdok mit den inzwischen zu Lofts umfunktionierten ehemaligen Lagerhäusern ist einen Besuch wert.
- 1018 Amsterdam
© Mario Savoia, Shutterstock
Im Osten Amsterdams schließt sich das noble, grüne Wohnviertel De Plantage an. Als der Grachtenring im 17.Jh. von West nach Ost angelegt wurde, gelangte man nicht über die Amstel hinaus. Östlich vom Fluss lagen stattdessen Gärten und Schiffswerkstätten, die erst im 19.Jh. durch ein großbürgerliches Wohnviertel und das Zollzwischenlager Entrepotdok ersetzt wurden. Heute zieht es Besucher v.a. wegen des Tropenmuseums, des Zoos oder des Botanischen Gartens ins grüne Wohnviertel. Aber auch das Entrepotdok mit den inzwischen zu Lofts umfunktionierten ehemaligen Lagerhäusern ist einen Besuch wert.
- 1018 Amsterdam
Waterlooplein Market
Märkte und Flohmärkte © Alexander Tolstykh, Shutterstock
Der einzige regelmäßige Flohmarkt der Stadt auf dem Waterlooplein. Hier findet sich alles Mögliche und Unmögliche, von Fahrradschläuchen über Weihrauchschwenker bis zu Lederjacken aus zweiter Hand.
- Waterlooplein, 1011 Amsterdam
- http://waterlooplein.amsterdam/
- info@waterloopleinmarkt.nl
© Alexander Tolstykh, Shutterstock
Der einzige regelmäßige Flohmarkt der Stadt auf dem Waterlooplein. Hier findet sich alles Mögliche und Unmögliche, von Fahrradschläuchen über Weihrauchschwenker bis zu Lederjacken aus zweiter Hand.
- Waterlooplein, 1011 Amsterdam
- http://waterlooplein.amsterdam/
- info@waterloopleinmarkt.nl
Kadijk
Restaurants- indisch
© Erik Schuut, Cafe Kadijk
Von außen sieht es aus wie ein normales Café, aber auf der Karte stehen bezahlbare Gerichte. Lecker ist v.a. die Makrele.
- Kadijksplein 5, 1018 AB Amsterdam
- http://www.cafekadijk.nl/
- info@cafekadijk.nl
© Erik Schuut, Cafe Kadijk
Von außen sieht es aus wie ein normales Café, aber auf der Karte stehen bezahlbare Gerichte. Lecker ist v.a. die Makrele.
- Kadijksplein 5, 1018 AB Amsterdam
- http://www.cafekadijk.nl/
- info@cafekadijk.nl
Waterlooplein
Geographical © Laura Balvers, Shutterstock
Der einzige regelmäßige Flohmarkt der Stadt findet auf dem Waterlooplein statt. Hier findet sich alles Mögliche und Unmögliche, von Fahrradschläuchen über Weihrauchschwenker bis hin zu Lederjacken aus zweiter Hand.
- Waterlooplein, 1011 AL Amsterdam
- +31 20 552 4074
© Laura Balvers, Shutterstock
Der einzige regelmäßige Flohmarkt der Stadt findet auf dem Waterlooplein statt. Hier findet sich alles Mögliche und Unmögliche, von Fahrradschläuchen über Weihrauchschwenker bis hin zu Lederjacken aus zweiter Hand.
- Waterlooplein, 1011 AL Amsterdam
- +31 20 552 4074
Mozes- en Aäronkerk
Touristenattraktionen © MAIRDUMONT
An der dem hl. Antonius von Padua geweihten Kirche wurde zwischen 1783 und 1841 gebaut. In den 1980er-Jahren war das katholische Gotteshaus Zufluchtsort für Obdachlose und Drogenkranke. 1991 wurde es nach sorgfältiger Renovierung als Begegnungsstätte und Ort für Ausstellungen wiedereröffnet.
- Waterlooplein 205, 1011 PG Amsterdam
- http://mozesenaaronkerk.nl/
- +31 20 233 1522
- info@santegidio.nl
© MAIRDUMONT
An der dem hl. Antonius von Padua geweihten Kirche wurde zwischen 1783 und 1841 gebaut. In den 1980er-Jahren war das katholische Gotteshaus Zufluchtsort für Obdachlose und Drogenkranke. 1991 wurde es nach sorgfältiger Renovierung als Begegnungsstätte und Ort für Ausstellungen wiedereröffnet.
- Waterlooplein 205, 1011 PG Amsterdam
- http://mozesenaaronkerk.nl/
- +31 20 233 1522
- info@santegidio.nl
Entrepot-Dok
Touristenattraktionen © Rainer Kiedrowski, DuMont Reisebildportal
Früher dienten die Magazine als Umschlagplätze für zollpflichtige Waren. Das Dock-Entrepôt, umgeben von schiffbaren Wasserstraßen, wurde im Rahmen eines Stadterneuerungsprogramms in Sozial- und Eigentumswohnungen umgestaltet.
- 1018 Amsterdam
© Rainer Kiedrowski, DuMont Reisebildportal
Früher dienten die Magazine als Umschlagplätze für zollpflichtige Waren. Das Dock-Entrepôt, umgeben von schiffbaren Wasserstraßen, wurde im Rahmen eines Stadterneuerungsprogramms in Sozial- und Eigentumswohnungen umgestaltet.
- 1018 Amsterdam
Amstelhoeck
Cafés © Rainer Kiedrowski, DuMont Reisebildportal
Grand Café mit einer der schönsten Terrassen, direkt an der Amstel. Leider ist das Essen nicht immer gut.
- Amstel 1, 1011 PN Amsterdam
- http://amstelhoeck.nl/
- +31 20 620 9039
© Rainer Kiedrowski, DuMont Reisebildportal
Grand Café mit einer der schönsten Terrassen, direkt an der Amstel. Leider ist das Essen nicht immer gut.
- Amstel 1, 1011 PN Amsterdam
- http://amstelhoeck.nl/
- +31 20 620 9039
Werfmuseum 't Kromhout
MuseenEtwas für Freunde der Seefahrt: Nur wenige Hundert Meter vom großen Schifffahrtsmuseum entfernt kann man eine Museumswerft besichtigen und einen Einblick in das Treiben auf einer Schiffswerft im 19.Jh. gewinnen.
- Hoogte Kadijk 147, 1018 BJ Amsterdam
- http://kromhoutwerf.nl/
- +31 20 625 0302
Etwas für Freunde der Seefahrt: Nur wenige Hundert Meter vom großen Schifffahrtsmuseum entfernt kann man eine Museumswerft besichtigen und einen Einblick in das Treiben auf einer Schiffswerft im 19.Jh. gewinnen.
- Hoogte Kadijk 147, 1018 BJ Amsterdam
- http://kromhoutwerf.nl/
- +31 20 625 0302
Verzetsmuseum Amsterdam
MuseenDas geschichtliche Museum dokumentiert Aktivitäten des Widerstandes gegen die deutsche Besatzung im Zweiten Weltkrieg bildhaft und stimmt nachdenklich.
- Plantage Kerklaan 61a, 1018 CX Amsterdam
- http://www.verzetsmuseum.org/
- +31 20 620 2535
- info@verzetsmuseum.org
Das geschichtliche Museum dokumentiert Aktivitäten des Widerstandes gegen die deutsche Besatzung im Zweiten Weltkrieg bildhaft und stimmt nachdenklich.
- Plantage Kerklaan 61a, 1018 CX Amsterdam
- http://www.verzetsmuseum.org/
- +31 20 620 2535
- info@verzetsmuseum.org
Bijbelsmuseum Amsterdam
MuseenIn den Grachtenhäusern von 1662 wird versucht, anhand von Funden aus Ägypten und dem Mittleren Osten die alttestamentarische Epoche zu rekonstruieren. Besonders eindrucksvoll ist das Treppenhaus mit mythologischen Deckenmalereien (1717) auf Leinwand von Jacob de Wit.
- Nieuwe Herengracht 18, 1016 CH Amsterdam
- http://www.bijbelsmuseum.nl/
- +31 20 624 2436
- info@bijbelsmuseum.nl
In den Grachtenhäusern von 1662 wird versucht, anhand von Funden aus Ägypten und dem Mittleren Osten die alttestamentarische Epoche zu rekonstruieren. Besonders eindrucksvoll ist das Treppenhaus mit mythologischen Deckenmalereien (1717) auf Leinwand von Jacob de Wit.
- Nieuwe Herengracht 18, 1016 CH Amsterdam
- http://www.bijbelsmuseum.nl/
- +31 20 624 2436
- info@bijbelsmuseum.nl
Éénvistwéévis
Restaurants- Fischgerichte
Der Name sieht kompliziert aus, bedeutet aber einfach "ein Fisch zwei Fisch" und sagt, worum es hier geht: frischer Fisch in allen Varianten, aber ohne Brimborium.
- Schippersgracht 6, 1011 TR Amsterdam
- http://www.eenvistweevis.nl/
- +31 20 623 2894
Der Name sieht kompliziert aus, bedeutet aber einfach "ein Fisch zwei Fisch" und sagt, worum es hier geht: frischer Fisch in allen Varianten, aber ohne Brimborium.
- Schippersgracht 6, 1011 TR Amsterdam
- http://www.eenvistweevis.nl/
- +31 20 623 2894
Outsider Art Museum
MuseenAußerdem unterstützt die Hermitage mit Ausstellungen und Ateliers sogenannte Outsider Artists, Künstler mit psychischen Störungen. Diese Ausstellungen sind wahre Psychotrips: wild, witzig, berührend und ein gutes Gegenprogramm zu den alten Meistern.
- Amstel 51, 1018 EJ Amsterdam
- http://museumvandegeest.nl/
- +31 23 541 0670
Außerdem unterstützt die Hermitage mit Ausstellungen und Ateliers sogenannte Outsider Artists, Künstler mit psychischen Störungen. Diese Ausstellungen sind wahre Psychotrips: wild, witzig, berührend und ein gutes Gegenprogramm zu den alten Meistern.
- Amstel 51, 1018 EJ Amsterdam
- http://museumvandegeest.nl/
- +31 23 541 0670
ARTIS - Groote Museum
MuseenDas Groote Museum widmet sich wirklich großen Fragen: Wo kommen wir her? Was macht uns zu dem, was wir sind? Wie stehen Menschen, Tiere und Pflanzen miteinander in Verbindung?
- Plantage Middenlaan, 1018 CZ Amsterdam
- http://www.grootemuseum.nl/
- +31 20 523 3670
Das Groote Museum widmet sich wirklich großen Fragen: Wo kommen wir her? Was macht uns zu dem, was wir sind? Wie stehen Menschen, Tiere und Pflanzen miteinander in Verbindung?
- Plantage Middenlaan, 1018 CZ Amsterdam
- http://www.grootemuseum.nl/
- +31 20 523 3670
National Holocaust Names Monument
TouristenattraktionenWirklich beeindruckend: In diesem Monument, entworfen vom Stararchitekten Daniel Libeskind, sind die Namen aller 102.220 Juden, Sinti und Roma verewigt, die aus den Niederlanden deportiert und ermordet wurden. Zwischen den Backsteinmauern der begehbaren Skulptur laufen einem unweigerlich Schauer über den Rücken.
- 1018 TZ Amsterdam
- http://www.holocaustnamenmonument.nl/
Wirklich beeindruckend: In diesem Monument, entworfen vom Stararchitekten Daniel Libeskind, sind die Namen aller 102.220 Juden, Sinti und Roma verewigt, die aus den Niederlanden deportiert und ermordet wurden. Zwischen den Backsteinmauern der begehbaren Skulptur laufen einem unweigerlich Schauer über den Rücken.
- 1018 TZ Amsterdam
- http://www.holocaustnamenmonument.nl/
Nationaal Holocaustmuseum
MuseenIm ehemaligen jüdischen Viertel befasst sich heute das Joods Cultureel Kwartier (JCK) mit jüdischer Geschichte, Kultur, Religion und Verfolgung.
- Plantage Middenlaan 27, 1018 DB Amsterdam
- http://jck.nl/
Im ehemaligen jüdischen Viertel befasst sich heute das Joods Cultureel Kwartier (JCK) mit jüdischer Geschichte, Kultur, Religion und Verfolgung.
- Plantage Middenlaan 27, 1018 DB Amsterdam
- http://jck.nl/
Dignita Hoftuin
Restaurants- türkisch
Das Frühstück ist eine immer noch weithin unterschätzte Mahlzeit. Nicht so bei dieser kleinen Kette, die von pochierten Eiern nach türkischer Art (Çilbir) bis zu Pfannkuchen mit Waldfrüchten üppig portionierte Gerichte auf den Teller zaubert.
- Nieuwe Herengracht 18a, 1018 DP Amsterdam
- http://eatwelldogood.nl/
- +31 20 370 2723
Das Frühstück ist eine immer noch weithin unterschätzte Mahlzeit. Nicht so bei dieser kleinen Kette, die von pochierten Eiern nach türkischer Art (Çilbir) bis zu Pfannkuchen mit Waldfrüchten üppig portionierte Gerichte auf den Teller zaubert.
- Nieuwe Herengracht 18a, 1018 DP Amsterdam
- http://eatwelldogood.nl/
- +31 20 370 2723
Smit & Voogt
Restaurants- international
Der Küchenstil des Lokals ist international.
- Plantage Parklaan 10, 1018 ST Amsterdam
- http://cafesmitenvoogt.nl/
- +31 20 737 0829
Der Küchenstil des Lokals ist international.
- Plantage Parklaan 10, 1018 ST Amsterdam
- http://cafesmitenvoogt.nl/
- +31 20 737 0829
Plancius
Restaurants- international
Das Restaurant "Plancius" ist bei Jung und Alt beliebt.
Der Küchenstil des Lokals ist international.
- Plantage Kerklaan 61a, 1018 CX Amsterdam
- +31 20 223 6946
Das Restaurant "Plancius" ist bei Jung und Alt beliebt.
Der Küchenstil des Lokals ist international.
- Plantage Kerklaan 61a, 1018 CX Amsterdam
- +31 20 223 6946
Bloem Eten En Drinken
Restaurants- international
Bei schönem Wetter gibt es die Möglichkeit, draußen zu sitzen.
Es handelt sich um ein Restaurant mittlerer Preisklasse. Ein Hauptgericht kostet ab EUR 14.00, ein Menü kostet ab EUR 20.00.Die aktuellen Preise können vor Ort erfragt werden. Es werden EC- und Kreditkarten akzeptiert.
Der Küchenstil des Lokals ist international.
- Entrepotdok 36, 1018 AD Amsterdam
- http://www.bloem36.nl/
- +31 20 330 0929
Bei schönem Wetter gibt es die Möglichkeit, draußen zu sitzen.
Es handelt sich um ein Restaurant mittlerer Preisklasse. Ein Hauptgericht kostet ab EUR 14.00, ein Menü kostet ab EUR 20.00.Die aktuellen Preise können vor Ort erfragt werden. Es werden EC- und Kreditkarten akzeptiert.
Der Küchenstil des Lokals ist international.
- Entrepotdok 36, 1018 AD Amsterdam
- http://www.bloem36.nl/
- +31 20 330 0929
MARCO POLO Reiseführer
Amsterdam
Buch, 21. Auflage · 17.95 €Unterwegs in der Stadt der Grachten mit dem MARCO POLO Reiseführer Amsterdam Du suchst größte Vielfalt auf engstem Raum? Dann komm nach Amsterdam! Die vielleicht kleinstmögliche Metropole der Welt vereint Alt und Neu, Ruhe und Action, Kleinstadtcharme und Weltbürgertum. Den Spagat schafft sie wunderbar: Zwischen den alten Grachtenhäusern, hübschen Brücken und Kanälen fühlst auch du dich sofort wohl. Und mit den Empfehlungen aus dem MARCO POLO Reiseführer steht deinem Stadturlaub oder Wochenendtrip nichts mehr im Weg!
Amsterdam erleben wie die Locals mit MARCO POLO Insider-Tipps und Erlebnistouren
„Gezellig“ ist der Amsterdamer. Das zeigt sich beim Chillen im quirlig-vollen Vandelpark genauso wie am Koningsdag Ende April, wenn die ganze Stadt bei Bier und Oranjebitter-Likör eine einzige große Freiluftparty wird. Feilsche doch mal in den IJ-Hallen auf dem größten Flohmarkt Europas oder mische dich im historischen Café Hoppe unter die Einheimischen!
Dein MARCO POLO Reiseführer Amsterdam begleitet dich überall hin und gibt dir die besten Tipps – damit dein Städtetrip genau das Erlebnis wird, das du dir wünschst.
ERLEBE LOS!

MARCO POLO Cityplan
Amsterdam
Karte, 6. Auflage · 8.50 €Der Marco Polo Cityplan Amsterdam im Maßstab 1:12.000 ist der ideale Begleiter für deinen nächsten Städtetrip. Eine Erlebnistour durch die Stadt? Eine Sehenswürdigkeit? Ein Restaurant? Mit den Marco Polo Empfehlungen findest du genau das, was du suchst. Diese detaillierte Karte enthält die wichtigsten Highlights und Sehenswürdigkeiten für die Stadterkundung: Eine kleine Karte für den großen Überblick.
Und das bietet die Karte im Detail:
Über die Region:
Amsterdam beeindruckt mit seiner Mischung aus historischer Architektur, lebendiger Kulturszene und internationalem Flair. Die Stadt bietet zahlreiche Museen, Grachten und urbane Erlebnisse. Zu den bekanntesten Sehenswürdigkeiten zählen das Rijksmuseum mit Werken von Rembrandt sowie der Vondelpark als grüne Oase mitten in der Stadt.
